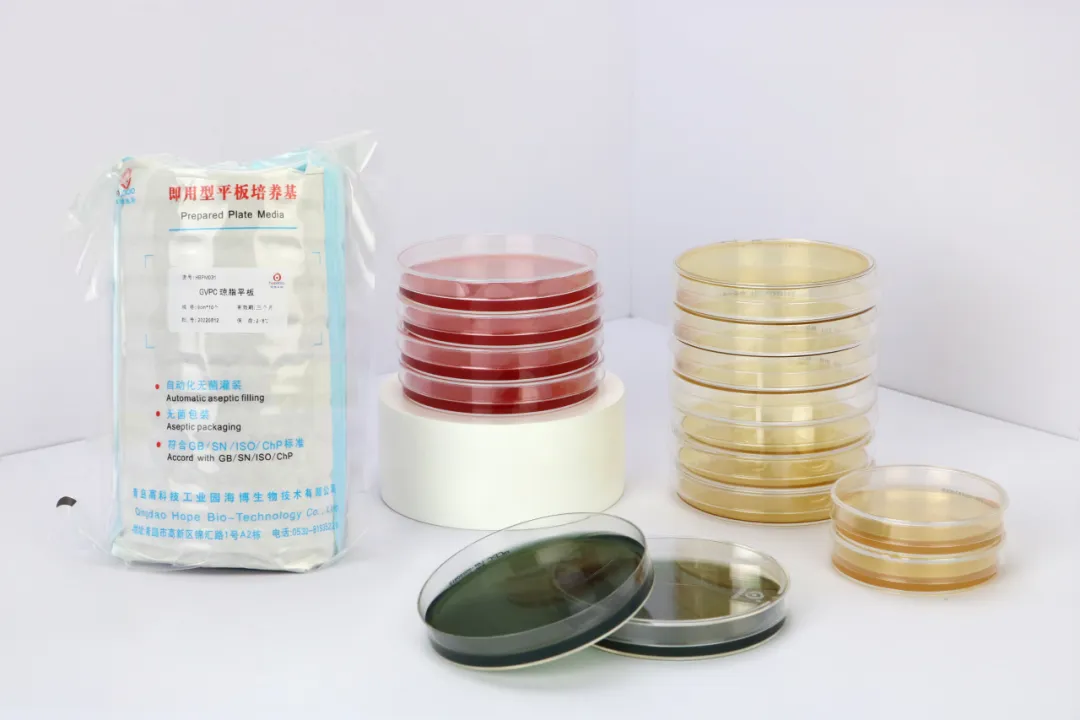
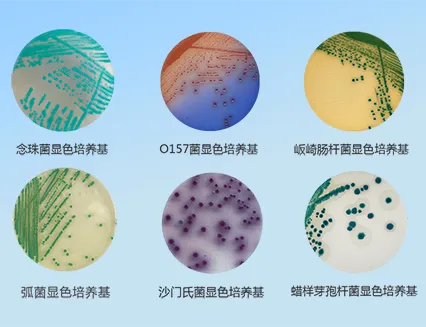

海博微信公众号
海博天猫旗舰店


在药品研发与生产的全链条中,微生物检测是守护药品安全、保障药效稳定的核心防线。深耕微生物检测领域26年的青岛海博生物,凭借全品类、高标准的产品矩阵与专业技术服务,已成为国内药品企业信赖的微生物检测解决方案核心供应商,深度赋能从创新药研发到规模化生产的全流程质控,在医药行业树立起“专业、可靠、高效”的标杆形象。
一、药典级标准护航,筑牢药企质控根基
药品生产对微生物检测的合规性、精准性、稳定性要求严苛,海博生物始终以中国药典、USP、EP、BP等全球权威标准为核心准绳,构建起覆盖药品全场景的药典级培养基与配套试剂体系。
沉降菌测试系列:大豆酪蛋白琼脂培养基(TSA)、TSA接触皿、沙氏琼脂培养基(SDA)、营养琼脂平板(NA)、RODAC培养皿等,精准适配药品生产车间洁净区环境监测、无菌车间沉降菌检测、浮游菌采样及表面微生物监控,全面满足药品GMP规范要求。

无菌检查及抑制剂效率检查:pH7.0氯化钠-蛋白胨缓冲液、0.1%蛋白胨水、磷酸盐缓冲液、胰酪大豆胨液体培养基(TSB)、硫乙醇酸盐流体培养基、玫瑰红钠琼脂、沙氏葡萄糖琼脂、R2A琼脂等,精准适配注射剂、 滴眼剂、无菌原料药等的无菌检查,以及口服液、外用制剂等需要添加防腐剂的药品抑制剂效率检查,确保检测结果符合药典规范。

微生物限度检查系列:麦康凯琼脂、沙氏葡萄糖琼脂、RV沙门菌增菌液体培养基、XLD木糖赖氨酸脱氧胆酸盐琼脂培养基、溴化十六烷三甲铵琼脂培养基等,高效检测口服药、外用药(如软膏、洗剂)等不需要绝对无菌,但需保证卫生安全的药品中的细菌、霉菌、酵母菌总数,控制微生物污染程度,精准筛查致病菌。


支原体检测系列:支原体肉汤/琼脂培养基、精氨酸支原体肉汤/琼脂培养基、支原体半流体培养基、PPLO肉汤/琼脂等,精准适配药品生产支原体污染检测、细胞培养及生物制品支原体检验,符合药典及国际标准,高效分离检出支原体,助力药企把控污染风险、保障药品质量,满足GMP合规要求。



抗生素检定系列:抗生素检定培养基1-9号、青霉素酶制备培养基等,为抗生素效价测定提供精准支撑,助力药企把控药品活性与质量。
即用型便捷产品:预制无菌平板、瓶装液体培养基、即用型袋装琼脂培养基、无菌采样袋等,即开即用、无需配制,大幅降低药企实验室操作误差,提升检测效率。



二、全品类产品矩阵,覆盖药企全生命周期需求
从新药研发的菌种筛选、工艺验证,到规模化生产的环境监测、成品检验,再到质量追溯的菌种保存,海博生物以2000 +种微生物检测产品,为药品企业提供一站式解决方案。
研发端赋能:显色培养基(如金黄色葡萄球菌、大肠杆菌显色培养基)、HBI微生物生化鉴定条,助力药企快速分离、鉴定目标菌株,加速新药筛选与工艺优化。

生产端保障:颗粒培养基、沉降菌测试用接触皿 、浮游菌测试培养基、无菌均质袋,适配药品生产车间环境监测、原辅料微生物检测、生产过程质控,确保生产环节无菌可控。


质控端升级:定量菌株(110-1100cfu/颗,精准定量)、瓷珠菌种保存管(-80℃超低温保存24个月,复苏成功率>95%)为药企实验室质量控制、菌种管理提供可靠工具。


智能设备加持:培养基速冷水浴复熔仪、智能试管分装仪、定量液体分装仪、凝胶强度测定仪等,推动药企实验室从传统操作向智能化、标准化转型,提升检测效率与数据准确性。
三、硬核实力背书,赢得药企广泛认可
海博生物的行业影响力,源于技术深耕、品质坚守与服务创新的三重实力:
研发与生产实力:国家级高新技术企业、专精特新企业,拥有2个专业的研发实验室、4个标准化万级洁净生产车间,建立严格的品质监控体系,确保每一批产品批批合格、稳定可靠。


合规与认证优势:率先通过ISO9001质量体系、GB/T29490知识产权管理体系认证,产品符合国内外数十项权威标准,可提供完整质控报告查询服务,助力药企顺利通过GMP、GSP等合规检查。


客户与口碑沉淀:产品覆盖全国数千家药品生产企业、研发机构与检验机构,从大型上市药企到创新型生物制药公司,海博生物与恒瑞医药、齐鲁制药、罗欣药业、绿叶制药、鲁抗集团、扬子江药业、复星医药、万泰生物等国内众多知名药企建立了稳定的合作关系。凭借稳定的产品质量、高效的技术响应、完善的售后支持,海博生物成为药企微生物检测领域的优选品牌。
四、携手药企,共筑药品安全新生态
药品安全无小事,微生物质控是底线更是责任。海博生物始终秉承“为药品安全保驾护航,助力药企高质量发展”的理念,持续加大研发投入,迭代升级产品与技术,为药品企业提供更精准、更便捷、更合规的微生物检测解决方案。
未来,海博生物将继续深耕医药微生物检测领域,以专业的产品、可靠的品质、贴心的服务,与全国药品企业携手同行,共同守护公众用药安全,推动中国医药产业向更高质量、更可持续的方向迈进!


上一篇:青岛海博生物祝您新年快乐!
下一篇:没有了!
